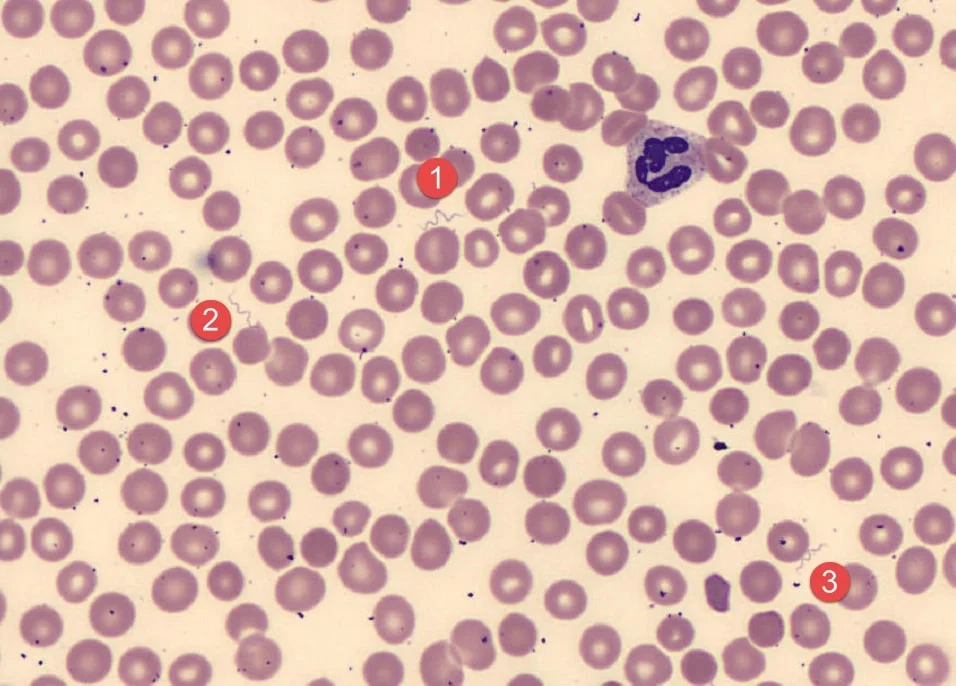

PROKARYOTIC PATHOGENS
1/43
There's no tags or description
Looks like no tags are added yet.
Name | Mastery | Learn | Test | Matching | Spaced |
|---|
No study sessions yet.
44 Terms

what is the organism
Bacillus anthracis
what disease does Bacillus anthracis cause
anthrax
pulmonary- wool sorters
gastrointenstinal- undercooked food
cuteneus
Bacillus anthracis details
gram pos, endospore pos, bacilli, central, aerobic to facultative
Bacillus anthracis recevoir
soil
Bacillus anthracis mode of transmission
inhaling or consuming spores, wounds
vaccine for Bacillus anthracis
yes

what is the organism
Clostridium botulinum
Clostridium botulinum disease
botulism, food poisoning, flaccid paralysis
Clostridium botulinum details
gram pos, endospore pos, bacilli, subterminal, strict anaerobe
Clostridium botulinum resevoir
soil
Clostridium botulinum mode of transmission
eating neurotoxin, badly stored food, raw honey, wounds
Clostridium botulinum vaccine?
no

what is the organism
Clostridium tetani
Clostridium tetani disease
tetanus, rigid paralysis
Clostridium tetani details
gram pos, endospore pos, bacilli, terminal, strict anaerobe
Clostridium tetani resevoir
soil
Clostridium tetani mode of transmission
contaminated wounds through spores on object
Clostridium tetani vaccine
yes

what is the organism
Corynebacterium diphtheriae
Corynebacterium diphtheriae disease
diphtheria, major organ failure, fatal
Corynebacterium diphtheriae description
gram pos, clubbed shaped bacilli, aerobic to slightly facultative
Corynebacterium diphtheriae reservoir
people
Corynebacterium diphtheriae mode of transmission
respiratory droplets, bacteria grows on back of throat and releases toxins into blood
Corynebacterium diphtheriae vaccine
yes
what is the organism
Borrelia burgdorferi
Borrelia burgdorferi disease
lymes disease, erythema migrans rash(bulls eye)
Borrelia burgdorferi description
gram neg, spirochete, microaerophilic
Borrelia burgdorferi resevior
rodents and birds
Borrelia burgdorferi mode of transmission
vector is deer ticks
Borrelia burgdorferi vaccine
no

what is the organism
Neisseria gonorrhoeae
Neisseria gonorrhoeae disease
gonorrhoeae, genital discharge and painful urination
Neisseria gonorrhoeae resevior
human, sexually transmitted disease
Neisseria gonorrhoeae mode of transmission
contact with infected mucous membrane of vaginal tract
Neisseria gonorrhoeae vaccine
no

what is the organism
Treponema pallidum
Treponema pallidum disease
syphilis
Treponema pallidum resevior
people
Treponema pallidum mode of transmission
direct contact with syphilis region
Treponema pallidum vaccine
no